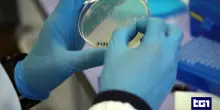
Le polemiche per la revoca del comitato sui vaccini

s

Primo Piano
Da Signorile a Chicchitto, nasce il Comitato Vassalli per il Sì
Ieri 02-11-25, 18:00
"Separare le carriere non è di destra, è conquista garantista"
CONTINUA A LEGGERE

11

0

0
Guarda anche
Ansa
Ieri, 23:55
Inter e Juve sono in orbita scudetto, il Milan stende la Roma
Ansa
Ieri, 23:38